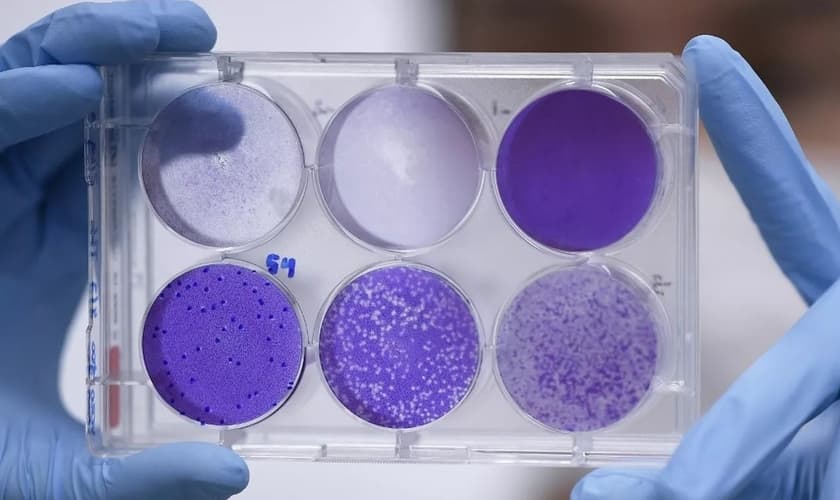
Material usado na pesquisa de uma vacina para o Covid-19 em Belo Horizonte, em imagem de 26 de março de 2020. (Foto: Douglas Magno/AFP)

O Brasil tem quase 200 voluntários inscritos em uma plataforma internacional que está convocando pessoas dispostas a se infectar de propósito com o novo coronavírus em testes múltiplos de vacinas.
A plataforma, chamada 1 Day Sooner, já tem 3,9 mil inscritos de 52 países. De acordo com os organizadores, até esta segunda-feira (27), 182 eram brasileiros.
Para desenvolver qualquer tipo de vacina, os cientistas precisam percorrer diversas etapas. Entre elas está a pesquisa básica – que é o levantamento do tipo de vacina que pode ser feita – seguida por testes pré-clínicos, que podem ser in vitro ou em animais e que servem para demonstrar a segurança do produto. Depois, há os ensaios clínicos, que ainda podem se desdobrar em outras quatro fases. Uma das mais demoradas é justamente o teste em humanos.
A iniciativa do 1 Day Sooner pretende ter à mão candidatos para testar diversos tipos de vacinas ao mesmo tempo – o que abrevia algumas etapas tradicionais para chegar a um resultado.
Atualmente, há 76 vacinas contra a Covid-19 sendo desenvolvidas, 71 em estágio pré-clínico e 5 em fase clínica,de acordo com um balanço da Organização Mundial de Saúde (OMS), com dados até 20 de abril.
“Nosso objetivo é criar as condições prévias necessárias para os testes avançarem, o que envolve garantir um conjunto diverso de voluntários pelo mundo”, afirma Josh Morrison, criador da iniciativa, em entrevista ao G1.
E m 31 de março, pesquisadores dos Estados Unidos e da Inglaterra publicaram um estudo científico no “Journal of Infectious Diseases” em que defendem os testes múltiplos em voluntários para acelerar o desenvolvimento de vacina contra Covid-19.
“Esses ensaios podem subtrair muitos meses do processo de licenciamento, disponibilizando vacinas eficazes mais rapidamente”, argumentam no artigo.
Os pesquisadores avaliam que os riscos de infectar voluntários com Covid-19 seriam amenizados se os testes forem feitos em pessoas que não estão em grupos de risco.
Os pesquisadores avaliam que os riscos de infectar voluntários com Covid-19 seriam amenizados se os testes forem feitos em pessoas que não estão em grupos de risco.
“Obviamente, ao desafiar voluntários com esse vírus, corre-se o risco de causar doenças graves e possivelmente até a morte. No entanto, argumentamos que tais estudos, ao acelerar a avaliação da vacina, poderiam reduzir o número global de mortalidade relacionadas ao coronavírus (...) o risco pode ser aceitável se forem feitos testes em adultos jovens e saudáveis, com risco relativamente baixo de doenças graves após infecção natural e se, durante o desafio, eles receberem monitoramento frequente e, após qualquer infecção, os melhores cuidados disponíveis”, afirmam.
Segundo a OMS, a iniciativa – chamada de Access to Covid-19 Tools Accelerator, ou o ACT Accelerator –, irá tornar as tecnologias contra a doença "acessíveis a todos que precisam delas, no mundo inteiro".
"O mundo precisa dessas ferramentas e precisa delas rapidamente (...) Estamos enfrentando uma ameaça comum, que só podemos derrotar com uma abordagem comum", afirmou Tedros Ghebreyesus, diretor-geral da OMS, no lançamento da iniciativa.
A OMS não cita os testes múltiplos, mas afirma que é preciso “testar todas as vacinas candidatas até que elas falhem.”
“A OMS está trabalhando para garantir que todos eles tenham a chance de serem testados no estágio inicial de desenvolvimento”, diz a organização.
Na última sexta-feira (24), a OMS lançou uma iniciativa de "colaboração emblemática" para acelerar o desenvolvimento, a produção e o uso de medicamentos, testes e vacinas seguros e eficazes para prevenir, diagnosticar e tratar a Covid-19.
Contribua mensalmente
com o GUIA-ME.
Somos um meio de comunicação cristão. Trabalhamos para informar com clareza e exatidão, sustentados por apuração responsável, revisão criteriosa e compromisso editorial.
Não atuamos como influenciadores de opinião, mas como jornalistas comprometidos com a verdade e os princípios de uma cosmovisão cristã.
O Guiame utiliza cookies e outras tecnologias semelhantes para melhorar a sua experiência acordo com a nossa Politica de privacidade e, ao continuar navegando você concorda com essas condições